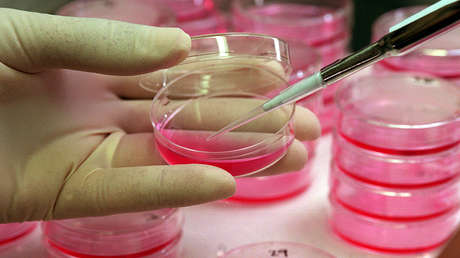
Descubren nuevo método de lucha contra uno de los cánceres más peligrosos

Un grupo de científicos estadounidenses ha demostrado que la regulación de ritmos circadianos podría tener un papel crítico en la lucha contra ciertos tipos de cáncer de hígado, informa Medical Xpress.
Los ritmos circadianos son un 'reloj' interno que tiene nuestro cuerpo; regulan el sueño, el metabolismo y otras funciones vitales del cuerpo. El sistema de este 'reloj' tiene un ritmo de 24 horas y opera en todas las células.
En su estudio, los científicos lograron inhibir el avance del cáncer de hígado en un ratón, manipulando su 'reloj circadiano' a nivel molecular. Luego los investigadores confirmaron el hallazgo en las muestras del tejido humano.
El equipo identificó una proteína defectuosa que inhibía la expresión de un factor clave de transcripción circadiana y bloqueaba la capacidad de los supresores tumorales de seguir su 'ritmo celular' de 24 horas. Cuando los investigadores forzaron a las células tumorales a volver a producir la proteína circadiana defectuosa, las células tumorales morían.
Según los expertos, el cincuenta por ciento de los tumores hepáticos producen esta proteína defectuosa, que induce la disfunción circadiana en las células.
El estudio se centró en el tipo de cáncer de hígado carcinoma hepatocelular (CHC), el tipo más común. Es la segunda causa principal de todas las muertes por cáncer relacionadas con la neoplasia.